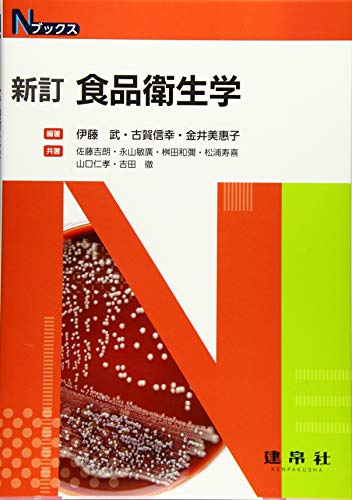

дјҠи—Ө,жӯҰ,йЈҹе“Ғ еҸӨиіҖ,дҝЎе№ё,1953- йҮ‘дә•,зҫҺжҒөеӯҗ,1952- дҪҗи—Ө,еҗүжң— ж°ёеұұ,ж•Ҹе»Ј гҒ»гҒӢ
пјҲ пјү
е®ҡдҫЎпјҡ2,860еҶҶпјҲ2,600еҶҶпјӢзЁҺпјү
еҲӨеһӢпјҡ
еҮәзүҲзӨҫгҒ®WebгӮөгӮӨгғҲгҒё launch
жӣёеә—еңЁеә«гӮ’гғҒгӮ§гғғгӮҜ
и‘—иҖ…з•Ҙжӯҙ
дјҠи—Ө, жӯҰ, йЈҹе“ҒпјҲгӮӨгғҲгӮҰ, гӮҝгӮұгӮ·гҖҖitou, takeshiпјү
еҸӨиіҖ, дҝЎе№ё, 1953-пјҲгӮігӮ¬, гғҺгғ–гғҰгӮӯгҖҖkoga, nobuyukiпјү
йҮ‘дә•, зҫҺжҒөеӯҗ, 1952-пјҲгӮ«гғҠгӮӨ, гғҹгӮЁгӮігҖҖkanai, miekoпјү
дҪҗи—Ө, еҗүжң—пјҲгӮөгғҲгӮҰ, гғЁгӮ·гӮӘгҖҖsatou, yoshioпјү
ж°ёеұұ, ж•Ҹе»ЈпјҲгғҠгӮ¬гғӨгғһ, гғҲгӮ·гғ’гғӯгҖҖnagayama, toshihiroпјү
жЎқз”°, е’ҢеҪҢпјҲгғһгӮ№гғҖ, гӮ«гӮәгғӨгҖҖmasuda, kazuyaпјү
жқҫжөҰ, еҜҝе–ң, 1958-пјҲгғһгғ„гӮҰгғ©, гғҲгӮ·гӮӯгҖҖmatsuura, toshikiпјү
еұұеҸЈ, д»ҒеӯқпјҲгғӨгғһгӮ°гғҒ, гғЁгӮ·гӮҝгӮ«гҖҖyamaguchi, yoshitakaпјү
еҗүз”°, еҫ№, 家ж”ҝеӯҰпјҲгғЁгӮ·гғҖ, гғҲгӮӘгғ«гҖҖyoshida, tooruпјү
гӮҝгӮӨгғҲгғ«гғЁгғҹ
гӮ«гғҠпјҡгӮ·гғ§гӮҜгғ’гғі гӮЁгӮӨгӮ»гӮӨгӮ¬гӮҜ
гғӯгғјгғһеӯ—пјҡshokuhin eiseigaku